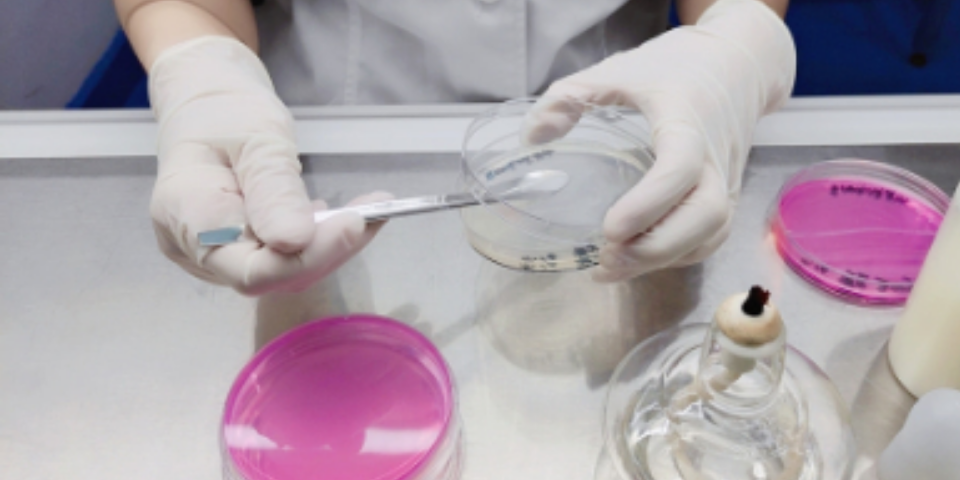
防止皮具防霉的措施

歡迎來(lái)到廣州簡(jiǎn)愷生物科技有限公司官網(wǎng)
133-6004-4175
139-2509-2502
微生物控制和防腐劑技術(shù)贏領(lǐng)者
專注防腐 · 防霉 · 抗菌產(chǎn)品研發(fā) · 生產(chǎn) · 定制
專注防腐 · 防霉 · 抗菌產(chǎn)品研發(fā) · 生產(chǎn) · 定制
熱搜關(guān)鍵詞: 常規(guī)防腐劑 皮鞋材防腐劑 洗滌抗菌防腐劑